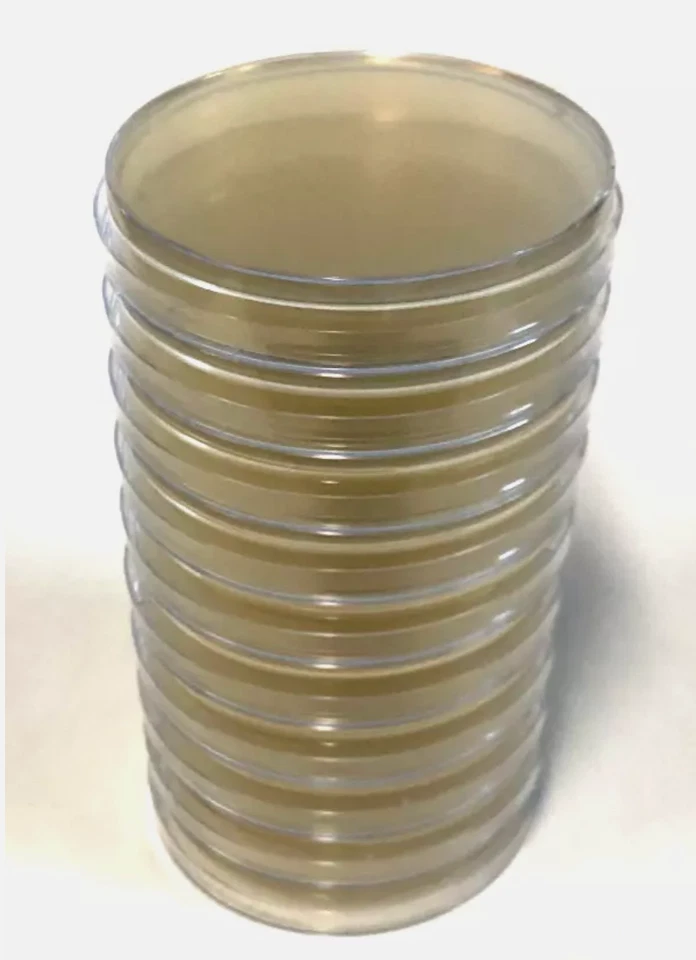
10x Pre-poured MEA (Malt Extract Agar) Agar Petri Dishes in 90mm Plates

MEA best sellers
Get a list of 107 MEA best sellers on Amazon, Ebay, Shopify and Wayfair . Period is past 7 days, last updated 2025-01-13.

|
#1 Ninja Dual Zone Air Fryer £11.99 on Amazon |
|

|
#2 🔥 🆕 B5/28 Antifungal & Antibacterial £15.99 on Ebay |
|

|
#3 🔥 🆕 Pound Notes Design Money £4.95 on Amazon |
|

|
#4 12x Pre poured MEA (Malt £15.99 on Ebay |
|

|
#5 B5/28 Antifungal & Antibacterial £24.99 on Ebay |
|

|
#6 FARCOM MEA NATURA Olive £11.49 on Ebay |
|

|
#7 🆕 B16 Head Lice & Mite £15.99 on Ebay |
|

|
#8 Letter Print Beanies £4.40 on Amazon |
|

|
#9 6 X 20 CC. Original Thai £33.27 on Ebay |
|

|
#10 MEA NATURA Olive 24 hour £17.49 on Ebay |
|

|
#11 MEA NATURA Olive Body £10.49 on Ebay |
|
|
#12 🆕 10x Pre poured MEA (Malt £16.99 on Ebay |
|

|
#13 High Sensitivity AC Coupling £5.24 on Ebay |
|

|
#14 MEA NATURA Olive Body £13.49 on Ebay |
|

|
#15 🔥 Pound Notes Design Money £7.89 on Amazon |
|

|
#16 MEA NATURA Olive Hand £7.99 on Ebay |
|

|
#17 🆕 Mea Natura Olive Moisturizing £29.02 on Ebay |
|

|
#18 B23 Itchy & Irritated £9.99 on Ebay |
|

|
#19 Indexable Combination £8.98 on Ebay |
|

|
#20 Mea Ola Mens £174.82 on Amazon |
Similar searches
Suggested best sellers
What's in Bestsellers.ai PRO ?
- 📊 Product Sales Estimates
- 💰 Total Sales Estimates
- 📜 Product Sales history
- 📅 52-Week Sales estimates
- 🔍 Advanced filtering
- ♻️ Second Hand and Refurbished market Data
Who uses Bestsellers.ai PRO ?
Trusted by e-merchants everywhere, Bestsellers.ai is their go-to for deciding what to sell next. Leading brands and retailers rely on us for crucial competitor insights and data-driven choices. 🚀
